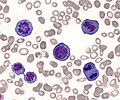

Category:Mitosis
Appearance
progression through the phases of the mitotic cell cycle, the most common eukaryotic cell cycle, which canonically comprises four successive phases called G1, S, G2, and M and includes replication of genome and subsequent segregation of chromosomes | |||||
| Upload media | |||||
| Instance of | |||||
|---|---|---|---|---|---|
| Subclass of | |||||
| Has part(s) |
| ||||
| Different from | |||||
| |||||
Subcategories
This category has the following 20 subcategories, out of 20 total.
A
C
- Cyclin B1 (7 F)
- Cyclin-dependent kinase 1 (11 F)
D
M
- Mitotic signaling (9 F)
P
- Preprophase band (9 F)
- Prometaphase (10 F)
S
T
Media in category "Mitosis"
The following 168 files are in this category, out of 168 total.
-
0300 Flourescence Stained.jpg 675 × 645; 225 KB
-
5 Makhluk Mitologi yang diyakini Dunia.pdf 1,500 × 843, 7 pages; 1.88 MB
-
-
Anaphase during Mitosis.svg 512 × 394; 32 KB
-
Attivazione MPF (semplice).png 1,067 × 449; 15 KB
-
Cell cycle (5 stages of mitotic cell life).jpg 2,200 × 500; 457 KB
-
Cell division according to A. Schneider (1873).png 1,262 × 357; 83 KB
-
Cell division according to E. Russov (1872).png 1,090 × 787; 98 KB
-
Cell division according to I. D. Chistyakov (1874).png 520 × 569; 52 KB
-
Cell division according to W. Flemming (1882).png 1,286 × 1,652; 414 KB
-
Cell division process.jpg 766 × 556; 30 KB
-
Cell polarity.jpg 181 × 160; 7 KB
-
Cell proliferation.jpg 1,557 × 876; 96 KB
-
Cervical AIS, ThinPrep.jpg 634 × 643; 212 KB
-
Chromatin bridge stained using DAPI 1.tiff 1,392 × 1,040; 4.14 MB
-
Chromosomes in mitosis and meiosis.png 396 × 373; 17 KB
-
Chromosomes2.jpg 256 × 256; 41 KB
-
Citodieresi.png 2,159 × 1,183; 155 KB
-
Cleavage Furrow Regression.svg 536 × 461; 11 KB
-
Cleavage Furrow Regression.tif 572 × 492; 19 KB
-
Com mROS contribueix a la senyalització mitogènica..gif 441 × 522; 787 KB
-
Complete network.jpg 1,391 × 867; 98 KB
-
CONDENSING CHROMOSOMES 2.jpg 1,935 × 549; 785 KB
-
Cormophyta alternancia-de-generaciones.png 192 × 192; 9 KB
-
Critique of the Theory of Evolution Fig 046.jpg 510 × 820; 94 KB
-
Cuerpo Flemming Asimetrica.jpg 680 × 900; 92 KB
-
Cuerpo Flemming Simetrico.jpg 692 × 900; 95 KB
-
Cuerpo Flemming Ubicacion.png 592 × 434; 276 KB
-
Cuerpo intermedio Flemming.png 1,912 × 560; 433 KB
-
Cytokinesis.png 280 × 302; 4 KB
-
Diagramatic illustration of the successive stages of mitosis (22699945268).jpg 1,890 × 2,385; 1.29 MB
-
Difference between Chromosome and Chromatid.png 1,528 × 850; 51 KB
-
Difference between chromosomes and chromatids.png 1,514 × 838; 110 KB
-
Diploid Cell.png 1,424 × 792; 121 KB
-
Division cellule.jpg 400 × 147; 69 KB
-
DNA Replication in Diploid Cell.png 1,425 × 799; 125 KB
-
EB1911 Cytology - heterotypical mitosis.jpg 760 × 277; 62 KB
-
EB1911 Cytology - maturation divisions (1).jpg 813 × 655; 171 KB
-
EB1911 Cytology - nuclear division.jpg 766 × 935; 274 KB
-
EB1911 Cytology - preparation for mitosis (2).jpg 891 × 421; 99 KB
-
EB1911 Cytology - preparation for mitosis.jpg 793 × 211; 52 KB
-
EB1911 Rhizopoda - Bud-fission of Euglypha alveolata.jpg 1,086 × 738; 307 KB
-
Embryo in flower.png 3,000 × 3,006; 2.97 MB
-
Figure 04.jpg 700 × 955; 104 KB
-
Figure 05.jpg 800 × 605; 65 KB
-
Figure 06.jpg 400 × 1,025; 56 KB
-
Figure 10 02 04.jpg 544 × 544; 173 KB
-
Fluxograma - atuação da pRb.jpg 896 × 873; 79 KB
-
Friedrich Reinke's medical school graduation document.jpg 1,575 × 1,959; 331 KB
-
Gray2.png 376 × 600; 19 KB
-
Gyhhhh.jpg 788 × 389; 32 KB
-
Interphase cycle- Mitosis and Meiosis.png 1,416 × 817; 284 KB
-
Interphase mitosis.png 508 × 149; 2 KB
-
Irreversible Bistable Switch in Mitotic Exit.jpg 960 × 633; 54 KB
-
MajorEventsInMitosis.jpg 460 × 167; 19 KB
-
MajorEventsInMitosistr.jpg 460 × 167; 19 KB
-
Malignant spindle cell neoplasm showing mitotic figures 40X.jpg 997 × 749; 287 KB
-
Malignant spindle cell neoplasm showing mitotic figures.jpg 997 × 749; 273 KB
-
Marine Fireworks.tif 3,456 × 3,456; 34.17 MB
-
Meiosis 1- Anaphase 1.png 995 × 728; 77 KB
-
Meiosis 1- Cytokinesis.png 1,661 × 803; 110 KB
-
Meiosis 1- Prophase 1.png 998 × 713; 63 KB
-
Meiosis 1- Telophase 1.png 629 × 733; 50 KB
-
Meiosis 2- Anaphase 2.png 1,372 × 725; 102 KB
-
Meiosis 2- Cytokinesis (2).png 1,322 × 777; 92 KB
-
Meiosis 2- Cytokinesis.png 1,322 × 758; 83 KB
-
Meiosis 2- Metaphase 2.png 1,370 × 726; 115 KB
-
Meiosis 2- Prophase 2.png 1,661 × 725; 67 KB
-
Meiosis 2- Telophase 2.png 1,372 × 725; 95 KB
-
Meiosis- Metaphase 1.png 630 × 727; 64 KB
-
Meiosis1- Cytokinesis.png 1,372 × 775; 81 KB
-
Metafase.png 1,489 × 1,489; 150 KB
-
Metaphase during Mitosis.svg 512 × 431; 49 KB
-
Mitoos.jpg 1,022 × 372; 58 KB
-
Mitoosi1.jpg 97 × 55; 3 KB
-
Mitoosi2.jpg 105 × 70; 4 KB
-
Mitoosi3.jpg 230 × 75; 5 KB
-
Mitos delar kromosomerna i en cellkärna..png 1,023 × 372; 127 KB
-
Mitose colchicine fr.svg 800 × 263; 135 KB
-
Mitose.gif 359 × 501; 4 KB
-
Mitose.JPG 691 × 600; 48 KB
-
Mitosiaren faseak - eu.svg 2,361 × 409; 1.16 MB
-
Mitosis (1).jpg 1,800 × 2,255; 929 KB
-
Mitosis (13083175463).jpg 595 × 842; 61 KB
-
Mitosis Animation.gif 1,200 × 675; 324 KB
-
Mitosis by Elspeth.jpg 1,440 × 1,175; 272 KB
-
MITOSIS cells secuencie-es.jpg 1,000 × 149; 49 KB
-
Mitosis cells sequence English.svg 774 × 115; 494 KB
-
Mitosis classification.png 683 × 734; 136 KB
-
Mitosis cycle.jpg 2,464 × 2,056; 2.87 MB
-
Mitosis In A Lymphoma Cell.jpg 715 × 667; 281 KB
-
Mitosis Mesenchymal Stem Cells.gif 300 × 253; 2.94 MB
-
Mitosis of onion cells.jpg 3,024 × 4,032; 2.4 MB
-
Mitosis process.gif 600 × 400; 120 KB
-
Mitosis schematic diagram-es.svg 833 × 723; 190 KB
-
Mitosis Stages.JPG 2,592 × 1,936; 2.21 MB
-
Mitosis stages.jpg 1,564 × 1,564; 1.23 MB
-
Mitosis variations protists eukaryotes.jpg 1,099 × 647; 124 KB
-
Mitosis vs Meiosis Daughter Cells.png 1,254 × 653; 156 KB
-
Mitosis- Anaphase.png 625 × 751; 54 KB
-
Mitosis- Cytokinesis (1).png 1,369 × 663; 84 KB
-
Mitosis- Cytokinesis.png 1,372 × 756; 69 KB
-
Mitosis- Metaphase.png 646 × 758; 71 KB
-
Mitosis- Prophase.png 1,491 × 831; 162 KB
-
Mitosis- Telophase.png 625 × 753; 36 KB
-
Mitosis-AscarisEggcs400x2.jpg 1,024 × 768; 140 KB
-
Mitosis.gif 1,024 × 768; 14.88 MB
-
Mitosis.jpg 158 × 142; 24 KB
-
Mitosis.png 576 × 528; 80 KB
-
MitosisAndMeiosis de.png 1,274 × 1,800; 23 KB
-
MitosisAndMeiosis en.png 1,274 × 1,800; 23 KB
-
Mitotic Catastrophe Diagram 2.png 2,958 × 1,664; 192 KB
-
Mitotic Catastrophe Diagram version 2.png 2,958 × 1,664; 186 KB
-
Mitotic Catastrophe Diagram.png 1,704 × 962; 99 KB
-
Mitotic checkpoint vertebrates.png 680 × 501; 18 KB
-
Mitotic LLC-PK1 cells, fluorescence microscopy (23700644352).jpg 1,800 × 1,200; 1.6 MB
-
Mitoticcellcycle.PNG 528 × 258; 9 KB
-
Network picture.png 346 × 259; 56 KB
-
Neuroblast cell division - 486169.fig.002a.jpg 600 × 207; 10 KB
-
Nondisjunction in Mitosis.jpg 479 × 473; 89 KB
-
Normal and multipolar mitosis.tif 1,024 × 1,024; 3.14 MB
-
Nuclear envelope breakdown and reassembly in mitosis.jpg 1,200 × 790; 142 KB
-
Onion cells under a microscope.jpg 2,268 × 4,032; 1.52 MB
-
Onion root cells.png 965 × 482; 1,012 KB
-
Onion Root Tip Cells Mitosis.jpg 2,592 × 1,944; 978 KB
-
Pair-pull-part mitosis and meiosis.png 1,021 × 716; 295 KB
-
Prophase diagram.svg 512 × 407; 46 KB
-
PSM V71 D104 Cells from the mouth of the salamander to show mitosis.png 1,387 × 2,060; 421 KB
-
Remak cell1.jpg 256 × 192; 11 KB
-
Rhodelphis edaphicus binary fission (DOTkamina).png 1,640 × 1,482; 591 KB
-
Rhodelphis mylnikovi. Binnary fission (DOTkamina).jpg 1,209 × 1,312; 49 KB
-
RPE Cell Taxol treatment - mitotic catastrophe.webm 8.9 s, 654 × 480; 1.8 MB
-
Securin phosphorylation sites2.jpg 407 × 198; 62 KB
-
Securin-separase conserved.png 345 × 258; 77 KB
-
Simplified network controls mitotic exit.jpg 960 × 633; 55 KB
-
Spindle Assembly Checkpoint.png 1,916 × 1,051; 306 KB
-
Spindle checkpoint vertebrates - en.png 960 × 720; 75 KB
-
Stages of ciliate conjugation.svg 1,222 × 920; 124 KB
-
Stages of early mitosis in a vertebrate cell (hy).svg 512 × 239; 69 KB
-
Stages of early mitosis in a vertebrate cell with micrographs of chromatids.svg 512 × 1,170; 458 KB
-
Stages of early mitosis in a vertebrate cell.svg 512 × 1,408; 156 KB
-
Stages of late M phase in a vertebrate cell.svg 512 × 1,593; 211 KB
-
StevensNM-StSp-1905-Pl-6-R12.jpg 1,336 × 578; 87 KB
-
StevensNM-StSp-1905-Pl-6-R34.jpg 1,336 × 586; 98 KB
-
StevensNM-StSp-1905-Pl-6-R56.jpg 1,336 × 637; 96 KB
-
StevensNM-StSp-1905-Pl-6-R70.jpg 1,336 × 321; 54 KB
-
Telofase.png 2,159 × 1,183; 143 KB
-
Telophase during Mitosis.svg 512 × 384; 55 KB
-
TelophaseSH.png 809 × 706; 51 KB
-
The events of the eukaryotic cell cycle.svg 512 × 256; 1.28 MB
-
The twin brothers.tif 10,836 × 10,011; 21.31 MB
-
Three cell growth types.png 499 × 507; 170 KB
-
Trije tipi celične delitve.svg 694 × 700; 235 KB
-
Tripolar Mitosis - breast carcinoma.jpg 2,048 × 1,536; 1.41 MB
-
Tripolar Mitosis - bronchial wash.jpg 1,238 × 921; 365 KB
-
Twelve sketches illustrating all successive stages of mitosis (23129542051).jpg 1,925 × 1,772; 1.26 MB
-
Types of mitosis.png 664 × 448; 121 KB
-
Whole Genome Doubled Instability.png 4,431 × 1,319; 667 KB
-
Wilson1900Fig1.jpg 1,388 × 1,201; 296 KB
-
Zellsubstanz, Kern und Zelltheilung Wellcome L0060921.jpg 6,666 × 4,620; 4.49 MB
-
Zellsubstanz-Kern-Kerntheilung.jpg 306 × 434; 36 KB
-
Événements majeurs de la Mitose es.png 460 × 167; 54 KB
-
Митоза (анимација).gif 865 × 579; 3.01 MB




.png)
.png)
.png)
.png)



















.jpg)




.jpg)

.jpg)





















.png)












.jpg)
.jpg)

.png)














.jpg)









..jpg)



.png)
.jpg)







.svg.png)













.jpg)




.gif)